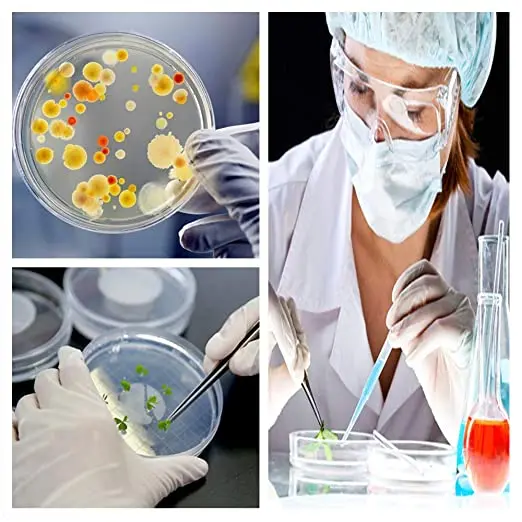
Medical-grade Gamma Sterilized Polystyrene Cell Culture Petri Dish

Medical grade Gamma Sterilized Polystyrene Cell Culture Petri Dish
- Category: >>>
- Supplier: Mdhc Life Technologies (kunshan) Co. Ltd.
Share on (1600640466972):
Product Overview
Description
Product Name
Wholesale Factory Direct Sale Plastic Cell Culture Petri Dish
Products Description

MDHC Petri Dish
Features:
* Top and bottom stacking rings for easier handling and more stable stacking
* Sterile and non-pyrogenic
* Available with or without air vents for gas exchange
* 2 x 2mm grid for cloning experiments and determination of plating efficiency
Warranty: 90 days
Applications
• promotes maximum adhesion for a broad range of cell types.
* Top and bottom stacking rings for easier handling and more stable stacking
* Sterile and non-pyrogenic
* Available with or without air vents for gas exchange
* 2 x 2mm grid for cloning experiments and determination of plating efficiency
Warranty: 90 days
Applications
• promotes maximum adhesion for a broad range of cell types.

Recommend Products
Details Images



Why Choose Us

ISO13485
Workplace Conditions Assessment
ISO9001
FAQ
Q:What is Petri dish for?
A: A petri dish is used to culture different types of cells, including bacteria and molds. It often contains a nutritional medium on. which the cells can grow. A petri dish is a flat, shallow dish made of glass or plastic with a suitable lid.
A: A petri dish is used to culture different types of cells, including bacteria and molds. It often contains a nutritional medium on. which the cells can grow. A petri dish is a flat, shallow dish made of glass or plastic with a suitable lid.
Q: What is in a Petri dish to grow bacteria?
A: Culturing Bacteria in a Petri Dish With Agar
Bacteria can be collected from just about any surface and grown in a substance called agar. By growing, or culturing, the
bacteria, it's easier to see what types are present and in what quantities.
A: Culturing Bacteria in a Petri Dish With Agar
Bacteria can be collected from just about any surface and grown in a substance called agar. By growing, or culturing, the
bacteria, it's easier to see what types are present and in what quantities.
1: What's the minimum order quantity?
The MOQ for this product is 1 Carton(In stock)
2: What's the production time?
That's depends on your quantity, usually takes about 10 days.
3: Can you send samples?
We can provide free samples, but the freight is supposed to pay by customers.
4: Can you produce according to customers' requirement?
Yes, we can provide OEM service according to your requirements.
5: What are your payment terms?
TT, L/C at sight, Western Union, DP and so on.
The MOQ for this product is 1 Carton(In stock)
2: What's the production time?
That's depends on your quantity, usually takes about 10 days.
3: Can you send samples?
We can provide free samples, but the freight is supposed to pay by customers.
4: Can you produce according to customers' requirement?
Yes, we can provide OEM service according to your requirements.
5: What are your payment terms?
TT, L/C at sight, Western Union, DP and so on.
Contact Us

We Recommend
New Arrivals
New products from manufacturers at wholesale prices